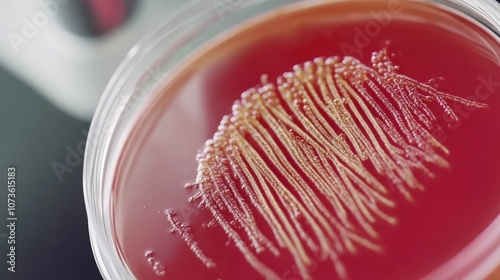

Download sample
File Details
Published: 2024-11-10 16:41:16.984686 Category: Graphic Resources Type: Illustration Model release: NoShare
Close-up of petri dish with diversestrains of gut bacteria,highlighting the significance of guthealth and microbiome diversity.
Contributor: SHI
ID : 1073615183
